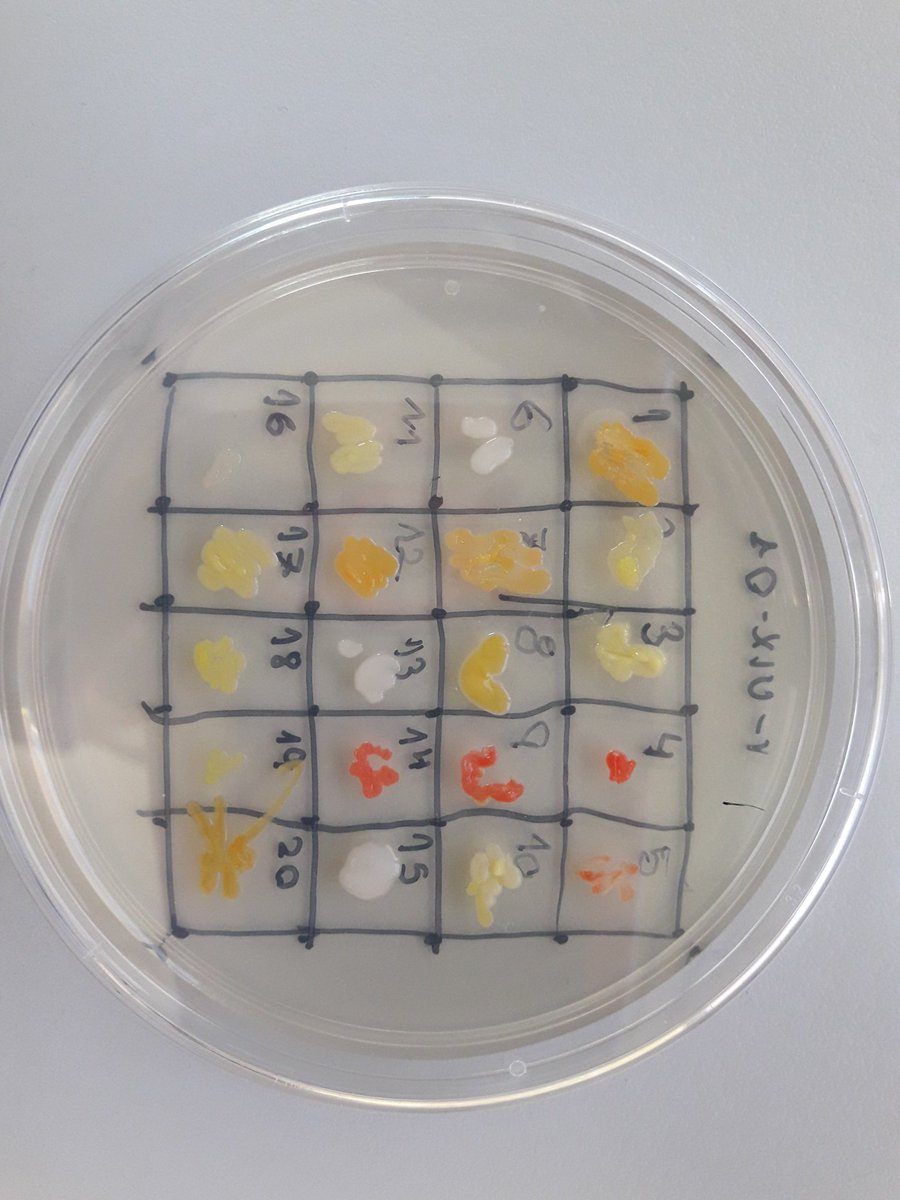
240 colònies aïllades a la Vall d'Uixó <a href="/iesbenigaslo/">IES BENIGASLÓ</a> preparades per assajar antibiosi en breu. Descobrirem un nou antibiòtic a la Plana Baixa? <a href="/SERlavallduixo/">SER la Vall d'Uixó</a> <a href="/ajlavallduixo/">Aj. La Vall d'Uixó</a> <a href="/sfpieuv/">Formació Permanent i Innovació Educativa</a> <a href="/CdCienciaUV/">UCC+i UV</a> <a href="/SWISpain/">SWISpain</a>

IES BENIGASLÓ
@iesbenigaslo
Institut d'Educació Secundària Benigasló
ID: 3089607099
12-03-2015 18:59:51
144 Tweet
311 Takipçi
1,1K Takip Edilen




Al tornar de les vacances de nadal comencem ja amb el programa Practica a l'UJI. Esperem que el gaudiu! uji.es/serveis/use/ba… #CiènciaUJI @UJI_noticies ArqTecnica UJI IES LA PLANA IES BROCH I LLOP IES MIRALCAMP IES XIMÉN D'URREA IES El Caminàs Violant de Casalduch IES BENIGASLÓ Colegio San Cristóbal



Així reaccionaven les xiques de l'IES Benigasló, de la Vall d’Uixó, en saber que havien guanyat el primer #rosquilletres ràdio 📻de la temporada. IES BENIGASLÓ


#VicentMartínezGuzmán més present que mai a les tertúlies #Intergenerational! #Setmanadelapau #pau IES BENIGASLÓ


La ràdio del centre és una aula més on el nostre alumnat desenvolupa les seves competències. Curset sobre l'ús educatiu de la ràdio. Amb Antoni Navarro 🍏📚 i IES BENIGASLÓ


IES BENIGASLÓ Antoni Navarro 🍏📚 Aprofiteu per presentar el projecte SWI que en breu iniciem al vostre centre!


Hui comencem el programa SWI als IES IES BENIGASLÓ de la Vall d'Uixó i IES Jaume II el Just a la Vall de Tavernes. Hui a SWI-VAL som SWI-VALL!


Lliçó de narració gràfica. Sento Llobell i Elena Uriel, jornades IES BENIGASLÓ. #CsCEFIRE. 5 anys per a fer un còmic. Formació, Innovació i Recursos per al Professorat "Te entran muchas dudas durante la creación. Días buenos y malos". 'Es más fácil dibujar cuando tienes documentos y objetos de época', Llobell dixit.


Projecte memorial, homenatge, amb les trinxeres de la Vilavella. Recuperar la memòria, com era la vida dels soldats? V Jornades Història Plana Baixa amb IES BENIGASLÓ i #CSCefire Patrimoni bèl.lic posat en valor


Hui farem sessions del SWI quasi simultànies a IES Jaume II el Just, @iesfmontseny, IES XIMÉN D'URREA i IES BENIGASLÓ Quien da mas?


240 colònies aïllades a la Vall d'Uixó IES BENIGASLÓ preparades per assajar antibiosi en breu. Descobrirem un nou antibiòtic a la Plana Baixa? SER la Vall d'Uixó Aj. La Vall d'Uixó Formació Permanent i Innovació Educativa UCC+i UV SWISpain

#clubdelectura #Internacional #biblioteca #LaValldUixó amb l'IES BENIGASLÓ i la residència de gent gran #HogarSagradaFamilia DES DE 2019!!


Mapa dels #NODES de la #Castellonada19: 📒#CSada19 #WMCP19 🗺️Jordi Sánchez Marín Manel Canseco Suárez Javier Soriano Martí 💻@PpMunozJ Tàfol Nebot 🚲 @[email protected] Carlos Llorens Barreda 📢#MòbilsON #fracturadigital 🌏Santi Navarro Sanz Francesc Guillem 🎭@ComQuedem Josep Rius Pérez 🗣️@CEFIREambitTIC Àmbit Artisticoexpressiu Castelló educa #CsCEFIRE


Alfred Ramos, hui a les #tertúlies #intergeneracionals #Biblioteca #LaValldUixó amb IES BENIGASLÓ IESBotànicCavanilles






